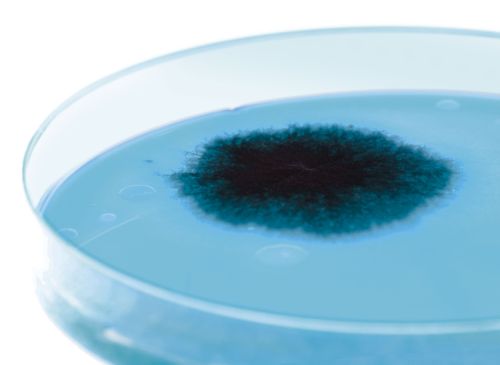

Antibiotika-Resistenz: Register abgelehnt
Der Nationalrat hat sich gegen ein Register entschieden, welches den Antibiotika-Einsatz im Tierbereich besser erfassen sollte. Es bleibt weiterhin im Dunkeln, in welchen Ställen die rund 57 Tonnen Antibiotika, die beispielsweise im Jahr 2012 zum Einsatz kamen, angewendet werden.
Der Nationalrat hat sich gegen ein Register entschieden, welches den Antibiotika-Einsatz im Tierbereich besser erfassen sollte. Es bleibt weiterhin im Dunkeln, in welchen Ställen die rund 57 Tonnen Antibiotika, die beispielsweise im Jahr 2012 zum Einsatz kamen, angewendet werden.
Der massive und zum Teil überbordende Einsatz von Antibiotika in der Tierhaltung und in der Humanmedizin führt dazu, dass sich weltweit immer mehr resistente Bakterien gebildet haben, bisher wirksame Antibiotika verlieren ihre Wirkung. Das ist eine sehr bedrohliche Entwicklung, der dringend ein Riegel geschoben werden muss.
Die Allianz der Konsumentenschutz-Organisationen der SKS, FRC und ACSI hat im letzten Herbst mit einem Test gezeigt, wie bedenklich die Situation bei Geflügelfleisch ist. Ein Register wäre eine wichtige Massnahme gewesen, um Erkenntnisse zu gewinnen, wo es problematische Anwendungsbereiche gibt. Leider hat der Nationalrat dies gestern abgelehnt. Er gibt dem Bundesrat aber immerhin die Kompetenz, Massnahmen zur Reduktion von Antibiotika-Resistenzen zu ergreifen.


